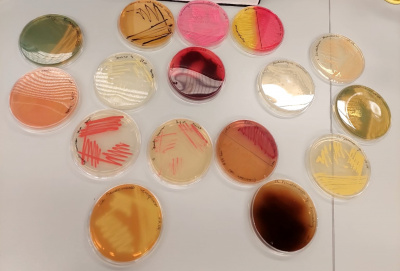
1

Participation in the Rector's Council, baking a pizza with the Dean, meeting with the world volleyball champion or a cruise on the Oceanographer - we invite you to take a look at all the auctions prepared by the UG community as part of the Great Orchestra of Christmas Charity.
The 32nd Grand Finale of the Great Orchestra of Christmas Charity will take place on Sunday, January 28, 2024. It will be dedicated to purchasing equipment for diagnosing, monitoring and rehabilitating lung diseases of patients in pulmonology wards for children and adults.
The University of Gdańsk community has prepared as many as 45 auctions on this occasion, which can be bid for via Allegro until January 31. Below are descriptions of the individual auctions. We encourage you to bid!

Participation in the Rector's Council combined with a visit to the House of the Abbots of Pelplin with the Rector's Team
The auction offers a unique opportunity to participate in a special Rector's Council, held in the recently renovated House of the Abbots of Pelplin in Gdańsk, at 3 Elżbietańska Street.
After the Council, the auction winner and their guests will go on a guided tour of the House of the Abbots of Pelplinsk under the guidance of the Rector's Team. Visitors to the historic house from 1612 will see beautiful frescoes, reconstructed carvings, newly discovered gilding of the portal and an 18th-century iron lantern that illuminated the interior of the House of the Abbots of Pelplin about 300 years ago.
The meeting will conclude with the presentation of a commemorative gift from the Rector's Team to the auction winner.
A convenient date for the meeting will be set by the bidding and exhibiting parties after the auction closes, but no later than the end of May 2024.
The auction winner will be able to invite three accompanying persons to the meeting.
Visit the beautiful, atmospheric interiors of the Elizabethan Street building before they are open to the general public and take part in a debate about the future of the University during the Rector's Council.

Prepare and eat pizza with the Dean of the Faculty of Social Sciences UG!
Bid for the unique opportunity to prepare a pizza with the Dean of the Faculty of Social Sciences prof. dr hab. Michal Harciarek, and enjoy it together in a relaxed atmosphere!
As part of the auction:
- You will spend time with the Dean of the Faculty of Social Sciences at the Faculty of Social Sciences 'Foodie' buffet to knead the dough, select the toppings and then bake a delicious pizza of your own creation!
- Once the preparation is complete, you will sit together at a table and chat about various topics over an informal dinner, enjoying the pizza you prepared. This is an ideal opportunity to get to know the Dean in a slightly more relaxed context.
The exact date of the meeting will be decided individually with the Dean, but no later than 31.06.2024. The preparation of the pizza and the dinner will take place in the late afternoon, after 'Foodie' buffet hours, to ensure an intimate atmosphere for the meeting.
One person will prepare the pizza with the Dean, but the auction winner can invite three accompanying persons to observe the preparation and share the meal. There will be enough pizza for everyone!
Don't miss the chance to bid for a unique and creative culinary adventure and enjoy the Italian atmosphere guaranteed in this auction.

Play a game of chess with the Dean of the Faculty of Mathematics, Physics and Computer Science of UG!
Bid for a unique opportunity to play chess with the Dean of the Faculty of Mathematics, Physics and Informatics prof. dr. hab. Piotr Bojarski in the Dean's office at the Faculty of MFI UG.
As part of the auction:
- You will spend time with the Dean of the MFI UG in his office at the MFI Faculty. You will see first-hand what the Dean's workplace looks like as he manages the UG unit responsible for the sciences;
- During the game, you will have the opportunity to talk to the Dean about topics of interest to you, all in the intimate atmosphere of the Dean's office over 'coffee and cake'.
The exact date of the meeting will be set individually with the Dean, but no later than 31.06.2024.
Don't miss the chance to bid for a unique opportunity to visit the Dean's office, face the Dean in a chess game and spend time in the company of the most important person at the UG MFI Faculty.

Play 'Splendor' with the Vice-Dean of the Faculty of Mathematics, Physics and Informatics UG!
As part of the auction, you will spend time in the company of the Vice-Dean of the Faculty of Mathematics, Physics and Informatics UG, prof. dr hab. Marcin Marciniak, UG in the 'Polufka' pub, playing the board game 'Splendor'. Together with the Vice-Dean and the other players, you will take on the role of Renaissance merchants who fight to win by investing in mines, improving transport and employing the best artisans.
During the game, you will have the opportunity to get to know the Vice-Dean more closely, talk to him about topics of interest, and, of course, try to beat him in a board game!
The auction winner can bring two companions to join the game.
The exact meeting date will be decided individually with the Pro Dean, but no later than 31.06.2024.
Don't miss the chance to bid for a unique opportunity to have a great time in the company of the Vice-Dean of the Faculty of MFI UG and the informal atmosphere of the 'Polufka' pub.

Play 'Boule' with the Vice-Dean of the Faculty of Mathematics, Physics and Computer Science of UG!
As part of the auction:
- You can face yourself individually or in a 2-person team with Ms Vice-Dean dr Barbara Wolnik in 'Boule' on the UG campus. You can invite 10 supporters to join the fun and cheer you on.
- You will spend time in the company of Vice-Dean of the Faculty of MFI UG dr Barbara Wolnik on the University of Gdańsk campus.
- During the game, you will have the opportunity to get to know Vice-Dean better and talk to her about topics of interest to you.
- After the game, Vice-Dean will invite all participants (including supporters) to her office for coffee and a cheesecake (no raisins!), which she will bake herself for the occasion.
The exact date of the meeting will be decided individually with Ms Vice-Dean, but no later than 15.06.2024.
The auction winner can take a companion with them to join the game.
Don't miss the chance to bid for a unique opportunity to have a great time in the company of the Vice-Dean of the Faculty of MFI UG and taste her famous cheesecake without raisins!

Meeting with World Champion Mariusz Wlazły over a cup of aromatic coffee
This auction is a real treat for every volleyball fan because you can win a unique experience: a meeting with Poland's representative, double World Champion in Men's Volleyball - Mariusz Wlazły!
In a cosy atmosphere, over a cup of aromatic coffee, you will talk to Mariusz about his path to sporting success, the ins and outs of playing volleyball - training, matches, victories and defeats - and listen to his memories of the most important tournaments. This is an opportunity to get to know the backstage of the volleyball world from the best source! In addition, you will receive a souvenir autographed by the volleyball player.
The meeting with the athlete, which will last about 30 minutes, will take place at a mutually convenient time in the 'Książką i Kawą' Café at the Faculty of Social Sciences of the University of Gdańsk.
Get closer to the world of volleyball than ever before! We invite you to bid for.
Mariusz Wlazły - World Volleyball Champion. In 2014, with the Polish national team, he won the gold medal at the World Championships and was named the most valuable player (MVP), as well as the best attacker. He has achieved many club and national team successes in his sporting career. Winner of numerous individual awards, he was recognised as the best volleyball player and attacker of the Champions League and Polish Cup. In 2022, he became the volleyball player of the 20th anniversary of the Polish Volleyball League. Awarded the Officer's Cross of the Order of Polonia Restituta (2014) and the Golden Cross of Merit (2006).
Since 2021, he has been a psychology student at the University of Gdańsk, and since the 2023/2024 season, he has been the coordinator of psychological preparation at Trefl Gdańsk.
He actively participates in social and charitable actions and cooperates, among others, with the 'Herosi', 'Możesz' and 'Dr. Clown' foundations. He is also president of his own foundation, created for children who want to play sports. In 2016, he was awarded the St. Brother Albert Medal for his support of people with disabilities.

Volleyball with the autograph of the World Champion - Mariusz Wlazły
This unique volleyball token can be yours!
Take part in the auction and win this exclusive ball with the autograph of Mariusz Wlazły - former volleyball player of the Polish national team with which he won the World Championship title, and currently a student at the University of Gdańsk.
Enjoy playing volleyball with your family and friends! Thanks to this ball, it will be even more fun - who knows, maybe even champion-like!

Time travel, or a ride in a 30-year-old ‘maluch’ (‘the little one’) around the Oliwa Campus of UG!
If you think that time travel is impossible, nothing could be further from the truth!
Bid for a ride around the grounds and surroundings of the Oliwa UG Campus in a 30-year-old Fiat 126p, 100% original (with black metal sheets and Stomil Olsztyn tyres), and you will see that for a moment, the old times are back. And if you have a driving licence, you will be able to drive the 'maluch' on the internal roads of the UG Campus. In addition, you will have the opportunity to take two extra people with you and take souvenir photos. It will also be possible to see documents and manuals for the car from the time of its production. The experience - the spaciousness of the place and the charm of the engine running - is priceless. A caveat - the ride will take place on an agreed date in the spring and summer, as the 'maluch' is currently in winter storage.
You will be taken along for the ride by a geographer who has been employed at UG for over 30 years and works at the Institute of Social and Economic Geography and Spatial Management. A traveller, lover of mountains, Iceland, old books, and one old car which is a family heirloom.
Take part in the auction and feel the automotive spirit of the old days!

Learn the secrets of creating Chinese calligraphy under the guidance of teacher Luo Ying at the Confucius Institute of the University of Gdańsk.
Chinese calligraphy is a traditional art that has carried the wisdom and aesthetics of Chinese culture for thousands of years. In this auctioned class, you will learn about the origin and evolution of Chinese characters and try the immersive practice of calligraphy with a special brush.
The length of the meeting is scheduled for 60 minutes. The workshop is aimed at a group of up to 8 people and is designed for both beginners and advanced participants.
Place: room 47 at the Confucius Institute of the University of Gdańsk (Jana Bażyńskiego 1A Street, 80-306 Gdańsk).
The workshop is conducted in English, Chinese and Polish with the support of an interpreter.
Luo Ying - a Chinese language teacher, has been teaching in Poland for three years and is a member of the Association of Chinese Writers.

A weekend full of relaxation in the Łączyn Resort
We invite you to bid for a weekend full of rest and relaxation in the Recreation Centre in Łączyn.
The auction concerns a stay in a cosy, 4-5-person cottage with a fireplace.
You can choose one of the following dates of your stay:
- 10-12.05.2024 r.,
- 17-19.05.2024 r.,
- 7-9.06.2024 r.
As a bonus, canoes and pedal boats can be used without restriction.
There is also an outdoor children's playground, billiards, table tennis, beach volleyball and a fire pit/grill area.
The property is located in a forested area at the Radunskie Dolne Lake.
This is a unique place for an exceptional rest - we invite you to bid.
Please get in touch with us at the telephone number provided after bidding. Arrangement of arrival date 14 days before the planned date.

Felted theatre by the University Kindergarten
Move into the world of fairy tales with a theatre made using the dry felting method! This method involves combining woollen fibre into a compact mass using a needle.
The object of the auction is the table theatre 'About a Dwarf and Grandmother', which includes five characters: a grandmother, a dwarf, an owl, a tit and a weasel, enabling free thematic play according to the scenario invented by the child. The theatre was made by children and teachers from the University Kindergarten in Gdańsk.
Playing theatre supports the acquisition of skills needed at later stages of a child's development, such as entering specific roles, contributing to better and easier social functioning. It shapes speech, expands vocabulary, develops imagination and creativity, and even strengthens family ties when the child's loved ones take on the role of actors in the theatre.
The University Kindergarten is inspired by the Reggio Emilia pedagogy method. An atmosphere of calm, closeness, and respect for each other and nature is nurtured, with the teacher accompanying the child in the process of self-inquiry and exploration. The child has an infinite number of ways to express himself and is viewed as strong, competent, creative, and full of potential.

An inspiring Design Thinking workshop with facilitators for you or your Team!
You have a unique opportunity to take part in an inspiring Design Thinking workshop with an experienced team of certified facilitators to build your skills in developing creative solutions. The auction is for a one-day class that will be designed with your goals, challenges and needs in mind, enabling you to develop your business idea and bring about positive change through an innovative approach.
You will have at your disposal a professional team of facilitators with extensive experience in delivering Design Thinking workshops, guaranteeing high-quality and effective training.
As a bonus, your company's logo and name will be included in the promotional materials for the workshop, increasing the awareness and reach of your business.
Venue: Faculty of Economics of UG or, upon agreement with the exhibitor, a convenient location provided by the bidder in the Pomeranian Voivodeship.
Date: The auction winner will have the opportunity to arrange a convenient date for the workshop.
An optimum number of participants: 5-15 people.
Time: The workshop will last one day and will cover a wide range of Design Thinking techniques adapted to the specific field of the auction winner's activity.
Workshop language: Polish or English.
At the end of the workshop, the auction winner and/or their team/organisation will receive an official certificate confirming their participation in the charity (WOŚP), which can be proof of social and business commitment.
Join our mission to foster innovation and growth through Design Thinking while supporting a worthy charity!

Cicero, Demosthenes, Aristophanes - a set for lawyers autographed by prof. Jerzy Zajadło
We are auctioning a set of three books written by prof. Jerzy Zajadło and dedicated to ancient Greek and Roman figures: the eminent speaker, military leader and philosopher Cicero, the speaker and politician Demosthenes, and the Greek comedian Aristophanes.
Referring to their works, Jerzy Zajadło not only points to the centuries-old humanist traditions that underpin modern universities but also seeks to draw inspiration from them for contemporary legal thought. Each book is enriched with the professor's autograph.
For more about the books, visit the UG Publishing House website.

‘Niepoznana. Gdynia i okolice do XII wieku’ edited by Mateusz Cwaliński and autographed by the authors
This year's GOCC auction features a unique - because autographed by the authors - copy of the book ‘Niepoznana. Gdynia i okolice do XII wieku’.
Archaeology and Gdynia are not commonly associated with each other, but with this book, we prove that they go hand in hand. The publication brings closer the earliest periods of history - the first arrivals and settlers in the area and their successors up to the Middle Ages. It reveals a part of our common past that has been little known and publicised so far. By characterising the natural conditions and vegetation, it allows the reader to better understand what drove the pioneers in prehistory when they decided to settle in the area of present-day Gdynia.
A group of outstanding experts worked on the volume: dr Mateusz Cwaliński, Karol Dzięgielewski, Mirosław Fudziński, dr Piotr Fudziński, Leszek Jurys, Danuta Król, prof. Małgorzata Latałowa, dr Anna Pędziszewska, dr Anna Strobin, prof. Szymon Uścinowicz, dr Sławomir Wadyl.
The co-publisher is the Museum of the City of Gdynia.
The book can be yours!
Book restoration demonstration at the book conservation workshop in the UG Main Library
The BUG conservation workshop is opening its doors for a good cause!
The auction winner will be able to visit the book restorer's workshop. They will see, among other things, how the paper pulp restoration machine works, how the cleaning equipment works, and what materials are used in conservation. In addition, they will learn what the work of a conservator consists of and what the various stages of conservation are.
This is a unique opportunity, as the workshop is not available on a daily basis!
Duration of the show: 1-1.5 hours.
Date: to be agreed.
The winner will be able to invite two additional accompanying persons.
Go behind the scenes and see how books are given a second life!

Special greetings in the ‘Gazeta Uniwersytecka’ magazine
Especially for you or your loved ones, we will include occasional wishes (birthday, name day, wedding, Christmas, anniversary or other) prepared by you or our editorial team on the back cover page of 'Gazeta Uniwersytecka - Czasopisma Społeczności Akademickiej Uniwersytetu of Gdańsk' (in one selected issue in the period March 2024 - June 2024 or October 2024 - February 2025).
PLEASE NOTE!
The journal is published in the second half of the month.
The winner of the auction is requested to contact the editors by e-mail (e-mail: gazeta@ug.edu.pl) at the latest by the middle of the month preceding the month of the issue of 'Gazeta Uniwersytecka' in which the wishes would appear. The content of the wishes and the graphic elements must not be contrary to the law, the rules of social coexistence (good manners) and the programme line of 'Gazeta Uniwersytecka'. They must not be advertising. They may not infringe on the good name and rights of third parties, including copyright, related rights, inventive rights, rights relating to trademarks and ornamental designs, rights relating to personal data protection, company secret rights, etc.

Box from around the world!
The International Cooperation Office, together with the Rector of the UG, has prepared for you a Box from Around the World in which every travel enthusiast will find something for themselves.
It is a collection of souvenirs, gifts, and gadgets collected during the Office's activities in various corners of the world. You will find in it:
- a plate from Uzbekistan presented to our University by Tashkent State University during the meeting of the Rectors of Poland and Uzbekistan in Tashkent in April 2023 - donated to the auction by the Rector of UG prof. dr hab. Piotr Stepnowski
- a table runner measuring 86x189 cm, donated to us by an alumnus from Bangladesh
- a photo album from the Maldives
- a ceramic container and a decorative picture - a gift from a guest from a partner university in Algeria
- chopsticks and a bookmark from a visit to China
- an illustrated book calendar for 2024 - a gift received from the Taipei Representative Office in Poland, containing interesting facts about Taiwan (in English and Chinese)
- a set of 9 postcards compiled during overseas missions
- a commemorative stamp issued on the occasion of the 100th anniversary of the renewal of diplomatic relations between Poland and Azerbaijan
- a book entitled ‘Utracone serce Azji’, in which Colin Thubron takes us on a unique journey through this fascinating corner of the world
The set is sure to appeal to all globetrotters!
The fascinating world of biotechnology - workshops at the Intercollegiate Faculty of Biotechnology UG and MUG
The Intercollegiate Faculty of Biotechnology at the University of Gdańsk and the Medical University of Gdańsk invites you to a workshop on the extraordinary world of biotechnology.
Let yourself be enchanted by science during an unforgettable walk through one of Poland’s most modern and unique Intercollegiate Faculty of Biotechnology UG and MUG. Take a peek into the biotechnology laboratory and take on the role of a scientist to experience first-hand the secrets of genetic engineering, microbiology, bioinformatics and molecular graphics.
The programme includes:
- popular science lecture 'The Colours of Biotechnology'
- a guided tour of the IFB UG and MUG
- workshops in the biotechnology laboratory
- workshops in the bioinformatics laboratory
Embark on this unique journey with IFB UG and MUG's passionate academic tutors: dr n. med. inż. Dorota Pomorska and dr Wioletta Żmudzińska.
Duration of workshop: 4-5h
Age of participants: 14+
The offer is intended for a group of max. 36 people who are fascinated by science and want to explore biotechnology.
Workshop date to be agreed upon with the auction winner.
The workshop level will be adapted to the age and knowledge of the participants - both beginners and advanced science enthusiasts are welcome!
Bid for this unique attraction for your class, school, company, family or friends and feel like real biotechnologists together.
See what last year's workshop was like, and play with us for the 2024 GOCC!
Do you have a question? Write to us: popularyzacja_nauki_mwb@ug.edu.pl

Photo session in the costumes of the Jantar Song and Dance Ensemble
We invite you to bid for a unique photo session in the Jantar Song and Dance Ensemble costumes!
The session will result in a minimum of 10 photographs, which will be donated in digital form. The shots will be taken in two different costumes, and there will be a choice of outfits in the patterns of Łowicz, Krakow, Kashubian, Lublin and Rzeszów. The session is intended for a couple or one person.
Venue: the building of the Academic Cultural Centre of the University of Gdańsk, 58 Wita Stwosza Street, Gdańsk.
Session duration: up to 2 hours. Offer for adults.

Private film screening at the Love Blonde DKF
Would you like to watch a good film on the big screen with your family and friends? Or maybe you fancy a relaxing cinema evening with friends?
In this year's auctions for the Great Orchestra of Christmas Charity, the UG Film Discussion Club Miłość Blondynki (Love Blondes) is putting up an opportunity to bid for a private film screening. The person who wins will invite their guests to the sensation. The organisers will take care of the atmosphere and offer a film surprise.
The screening will take place in the cinema hall on the UG campus on a date jointly chosen with the auction winner. In addition to the cinematic excitement, the cinema package must include popcorn and film goodies from the UG Film Discussion Club Love Blonde!
Bid on a film screening just for you!
To be used until the end of 2024.

Personalised Happy Birthday sung especially for you by the UG Choir
Especially for you or someone close to you, the UG Academic Choir will sing 'Happy Birthday' and send a personalised video to your e-mail address on your birthday.
UG Academic Choir is one of the most respected academic choirs in Poland. It has existed since 1971, invariably presenting a very high level of performance. It has won many awards at Polish and international festivals and competitions, travels, gives active concerts and is not afraid of exciting challenges.
Make your birthday celebration memorable.

A package full of original SEA-EU goodies!
There has never been an auction like this before! Enjoying extraordinary popularity, these beautiful author's gadgets from the SEA EU series can be yours.
They owe their uniqueness to the use of motifs from a collection of paintings by Professor Aneta Oniszczuk-Jastrząbek, which were created as a result of inspiration from trips to coastal universities as part of the SEA-EU project.
Brussels, Cadiz, Split and Malta are some of the European cities whose painterly reflections you will find in the auctioned set.
As part of the package, waiting for you are:
- Silk scarf
- Silk scarf
- Espresso cup with saucer
- Two paintings (each measuring 19.7 x 30 cm)
- A jigsaw puzzle (600 pieces, target size when completed: 42 x 60 cm)
- Set of 6 cork coasters for mugs
- Set of 10 bookmarks
Aneta Iwona Oniszczuk-Jastrząbek - born in Gdynia, is a professor at the University of Gdańsk in the field of economic sciences. She came into contact with professional painting in 2012. She is inspired by contemporary painting in her works, reaching for techniques based on abstraction and minimalism. Professor's painterly way of seeing reality is not reality as it is but seen through stories, colours, and emotions.
On October 3, 2022, she opened her first painting exhibition at the University of Gdańsk entitled 'SEA EU by the Sea. SEA EU coastal universities'. The opening of the exhibition was part of the Inauguration Ceremony of the Academic Year 2022/2023 at the University of Gdańsk.
Take away a painterly piece of Europe encapsulated in these unique souvenirs.

Silver earrings with a nautical motif from the limited edition SEA EU series.
Every woman will be delighted to wear these beautiful and extremely elegant earrings.
The jewellery was created in the atelier of 'Ewa Saj Design'. It was made in 925 sterling silver with the author's reproduction of a fragment of a painting work by Professor Aneta Oniszczuk-Jastrząbek entitled 'Baltic - our sea'.
The set is packaged in an ecological box with a fragment of the painting reproduction on it.
Aneta Iwona Oniszczuk-Jastrząbek - born in Gdynia, is a professor at the University of Gdańsk in the field of economic sciences. She came into contact with professional painting in 2012. In her paintings, she is inspired by contemporary painting, reaching for techniques based on abstraction and minimalism. Ms PAS's painterly way of seeing reality is not reality as it is, but seen through stories, colours and emotions.
On October 3, 2022, she opened her first painting exhibition at the University of Gdańsk entitled 'SEA EU by the Sea. SEA EU coastal universities'. The opening of the exhibition was part of the Inauguration Ceremony of the Academic Year 2022/2023 at the University of Gdańsk.
Beauty, excellent quality and exceptional design - these are the qualities that perfectly describe the jewellery set you can own.

Silver cufflinks with a nautical motif from the limited SEA EU series
This auction is the perfect opportunity to complete your men's wardrobe with this special set of sterling silver cufflinks.
They were created in the atelier of 'Ewa Saj Design', which made jewellery in 925 sterling silver. At the personalised order of the University of Gdańsk, the set was enriched with the author's reproduction of a fragment of Professor Aneta Oniszczuk-Jastrząbek's painting entitled 'Baltic - Our Sea'. 'The Baltic - our sea'.
Aneta Iwona Oniszczuk-Jastrząbek - born in Gdynia, is a professor at the University of Gdańsk in the field of economic sciences. She came into contact with professional painting in 2012. She is inspired by contemporary painting in her work, reaching for techniques based on abstraction and minimalism. Professor's painterly way of seeing reality is not reality as it is but seen through stories, colours and emotions.
On October 3, 2022, she opened her first painting exhibition at the University of Gdańsk entitled 'SEA EU by the Sea. SEA EU coastal universities'. The opening of the exhibition was part of the Inauguration Ceremony of the Academic Year 2022/2023 at the University of Gdańsk.
These elegant and unique pins are an absolute must-have for a man who wants to feel really special.

Hiking and sports package of university goodies
Do you enjoy physical activity, walking, or perhaps hiking is an integral part of your life? Take part in the auction, and this carefully selected, varied and convenient set of UG gadgets could be yours.
As part of the hiking and sports package, you will find:
- Backpack
- Nordic Walking poles
- Thermal mug (450 ml)
- Plastic bidon
- Waist bag
- Quick-dry sports towel (80x140 cm)
- Football (size 5)
- Baseball cap (universal size)
- Keyring
Bid on our promotional package - an excellent opportunity to complete your gear! And at the same time, contribute to the fight against sepsis!

Coffee & forest bathing (shinrin yoku) with the psychologists
Go for a coffee and an unusual walk in the forest - a forest bath (shinrin yoku) - with the psychologists of the UG Academic Psychological Support Centre.
Shinrin yoku is the practice of mindfully immersing oneself in nature using all the senses. It has its roots in Japan but has already been spread around the world because of its benefits for mental and physical health. Reduced stress levels, improved mood, lower blood pressure, boosted immunity, and higher energy levels - all proven by scientific research!
You can bring a companion to the meeting with the psychologist.
Meeting locations: Coffee @ Café LAS in Sopot.
The completion date is to be agreed upon individually but no later than 30.12.2024.
Agata Rudnik - a psychologist at the UG Academic Psychological Support Centre and academic teacher at the UG Institute of Psychology, also works at the hospital and counselling centre with, among others, people struggling with intestinal illnesses, personality disorders, and symptoms of anxiety and depression. Unconditionally in love with the Nordic countries.
Emilia Ożgo - a psychologist at the Academic Psychological Support Centre UG, teacher, researcher, and therapist in the solution-focused therapy stream. Mindfulnes passionate and trainer who cannot live without running, forest walks, books and travel.
Experience a new dimension of communing with nature!

Merino wool headband - custom-made
Bid on a headband handmade from merino wool that will effectively protect your head and ears from the cold and wind.
Made with English stitch, it is pleasant to the touch, lightweight, does not wrinkle or stretch, is durable and, most importantly, keeps you warm. Perfect for both a walk by the sea and around town.
Do you want a specific colour to match your jacket, scarf or gloves? It is possible. Order the headband in one colour of your choice*! You don't have to worry about the size either - the headband is 'tailor-made', so it will definitely fit you!
Don't like wearing hats? Looking for a fashionable accessory or a gift for a loved one?
Don't hesitate to bid and support GOCC from UG! The auction comes courtesy of the UG Faculty of Management.
*The auction concerns a single-colour headband. It is not possible to order a multi-coloured band.

Set of fascinating low fantasy books from the 'Patrycjuszka' series (1st & 2nd volume) autographed
The object of the auction is a set of 2 fascinating low fantasy books from the 'Patrician' series (the first and second volumes of the trilogy) with accessories from the universe (bookmarks, postcards, magnet) and an autograph.
The editions are enriched with the author’s illustrations and a map. Volume II also includes a character index and glossary.
„Patrycjuszka, tom I. Choćby na koniec świata”
How far will a young patrician go to save her beloved one who has disappeared under mysterious circumstances? Will the most expensive hireling in the Middle Lands - a representative of the ancient Amain race - prove to be worth the price? Who will return alive from the expedition to the end of the world? Love, betrayal, political intrigue, unusual peoples, a murderous trek through the Wilderness and a unique reptile, the viperun - this awaits you in the book 'Patrycjuszka. Choćby na koniec świata'.
„Patrycjuszka, tom II. Jestem Tessaro”
The Patrician is determined to free a mercenary who has fallen into the hands of conspirators through her cause. The political situation becomes more complicated, the intrigue, discovered by chance, is growing wider and wider, and more and more innocent people find themselves in mortal danger. What will be the further fate of Eurein Tessaro and her companions?
Karolina Żuk-Wieczorkiewicz - self-publisher by choice, illustrator and graphic designer after hours. A graduate of psychology at the University of Gdańsk and graphic design at the Academy of Fine Arts in Gdańsk. Currently works in the Office of the Dean of the Faculty of Social Sciences. Creates and illustrates stories in her own universe.

'Tangled identity' - signed drawing
Tangled in rhizomes and branches, the anxieties of a young woman in search of her own identity are the motif of the drawing entitled 'Tangled identity', which is the subject of this auction.
Signed by the author, the drawing was made in pencil on paper in a 50 by 70 cm format. It does not have a frame.
Dr Małgorzata Karczmarzyk, a member of staff at the Institute of Pedagogy (Media Education Studio), combines artistic and didactic activities due to her two areas of interest and double education (pedagogy at the UG and painting at the Academy of Fine Arts). She writes articles and books, paints, takes photographs, and creates pedagogical-artistic, theatrical, didactic and art-therapeutic projects, and as an artist, she is open to every possible creation.

Five albums by Tune 4 Tune (T4T), a band co-founded by prof. Marcin Szulc
Listen to a sound in the style of American hard rock, grunge and NWoBHM. Five discs of great music by the band Tune 4 Tune are waiting for you!
The band Tune 4 Tune (T4T), co-founded by prof. Marcin Szulc, was established in Gdańsk in 2011. T4T has many successes to its credit. In March 2014, it received the Audience Award in the Music Bend competition, and the nominated song was included on the compilation CD auctioned in this auction. In June 2014, Tune 4 Tune reached the final of the Life On Stage competition in Krakow, Poland, and in May the following year, they were among the winners of the Amplifier II competition.
The band has shared the stage with such notables as:
Apteka, Bregma, Calista, Crew, Chassis, Enej, Kamil Bednarek, Kozak System, Kult, Maleo Reggae Rockers, Mechanizm, Proletaryat, Trupa Trupa, W8
The band consists of:
- Piotr Horbaczewski - vocals
- Marcin Szulc - lead guitar
- Zdzisław Miszke - rhythm guitar
- Michał Żyliński - bass
- Jarosław Zych - drums
- Radosław Kruszyna - keyboard
Dr Marcin Szulc, prof. UG - psychologist, university professor at the Department of Personality and Forensic Psychology of the Institute of Psychology, University of Gdańsk. His scientific interests revolve around issues of adolescence and social risks. He is also a fan of heavy rock sounds. He uses his free time creatively as a guitarist and composer in the band Tune 4 Tune.

Relaxation meeting on the mat.
Bid for a personalised relaxation session under the guidance of a certified teacher - during the session, you will integrate gentle movement with conscious breathing.
Relaxation yoga is beneficial in times of increased stress and fatigue. It does not require much effort or the ability to perform advanced postures. The focus is on comfort and relaxation.
During the session, you will learn mindful, long and deep breathing to calm your mind and soothe your nervous system. You will move effortlessly into positions that will help you relax your body. Under the guidance of your teacher, you will use props in the form of blocks, bolsters and blankets, all designed to make you as comfortable as possible.
The classes are aimed at everyone. The only condition is that there are no medical contraindications to the activity (for any reason).
The meeting will occur in Magda's space, in the Science and Technology Park (Gdynia Redłowo). The completion date is to be agreed individually with the auction winner, but no later than 31.12.2024. All you need to bring is comfortable clothing.
Practitioner - Magdalena Herzberg-Kurasz
Yoga Alliance certified yoga teacher and breathing pattern re-education trainer trained under Sandra Osipiuk-Sienkiewicz. She regularly improves her qualifications by participating in workshops and trainings that are a source of inspiration for her practice. She emphasises the breath and the anatomical aspect of yoga postures in her yoga practice.
On a daily basis, she is an assistant at the Institute of Sociology, University of Gdańsk.

British pronunciation workshop
Want to work on your British English pronunciation but don't know where to start? Have you tried online courses but lack feedback? Do you like pronunciation based on the standard British model (Received Pronunciation)?
If so, then this auction is for you!
During the workshop, the participant will be able to choose to explore one of the following topics:
- the differences between British and American pronunciation
or
- an element of English - the three vowels
or
- the three consonants element of English
or
- a word accent
In addition, the presenter will introduce online sources to use in self-study of British pronunciation.
The workshop is aimed at one high school-age or adult who has intermediate (B1-B2) or advanced (C1-C2) level English and would like to learn selected aspects of British variety pronunciation. The accent taught is modern Received Pronunciation codified pronunciation.
The workshop will take place in the presenter's office in the Neophilology building at the Faculty of Languages, UG (51 Wita Stwosza Street). Upon the participant's request, the workshop can be held remotely via the Teams platform (people from UG) or Google Meet. The participant may choose English or Polish as the primary language for the workshop.
The completion date is to be agreed upon individually but no later than 30.06.2024.
The workshop will last 90 minutes.
Workshop leader:
Dr Maciej Rataj - works at the Institute of English and American Studies at UG. He is the author of approximately 20 publications in the field of sociolinguistics, including on the social aspects of English pronunciation in English-speaking countries. He is also interested in the methodology of teaching English pronunciation. He is co-author of the 2020 SuperMemo publisher's courses: 'Say It Better. British English', 'Say It Better. American English' and their Polish-language version 'Say It Better. English'. For the past few years, she has been presenting papers on English pronunciation at industry conferences for language teachers.
Don't delay! Bid for the workshop and practice British pronunciation under the guidance of dr Maciej Rataj!

A semester of Japanese language course
Japan - the Land of the Rising Sun- has a culture, architecture, customs, and language utterly different from ours. You can now learn the latter, thanks to this auction!
We would like to invite you to participate in the auction of 1 semester of a Japanese language course at the Foreign Languages Centre of the University of Gdańsk. This is the perfect opportunity to start your adventure with Japanese from scratch!
Course Details:
Number of meetings: 15 (once a week)
Meeting duration: 90 minutes
Start: summer term (scheduled from 19.02.24)
Meeting times: Monday to Friday, 16:00 - 20:00
Course group: 5-12 people
If the course times are inconvenient for you or the group does not form, you can exchange the course for another one from FLC UG's offer.
If you cannot use the course, you can also gift it to another person.
Please note: This auction, as one of the few held by the University of Gdańsk, lasts until the end of January!
It's time to go on a linguistic journey to the Far East!

'The speechwriter profession' - how are White House speeches made, and what should every speaker know about it?
- Are you looking for practical knowledge about public speaking, particularly in an English-speaking environment?
- You prepare speech content on a daily basis, but you find speaking in English a challenge?
- Do you actively participate in conferences and meet-ups, speaking in English?
- Are you interested in the behind-the-scenes work of communication professionals in significant centres of power?
If the answer to any of the above questions is 'YES', this auction is for you!
During the 90-minute meeting, you will learn about the process of creating a speech from the point of view of a speech writer. You will learn more about speeches, their types, purposes and how to organise the text. You will hear about the ins and outs of the work of speechwriters in the White House and other centres of power in Europe and find out how important the role of the speaker himself is in the process of creating a speech.
A particular highlight of the meeting will be the opportunity to inspect copies of speeches and related materials produced at the White House - a real gem!
The meeting can be held in both Polish and English.
The only requirement is knowledge of English to read the archive material's content.
Meeting venue: UG Oliwa campus
Completion date: to be agreed individually with the auction winner, but no later than 31.12.2024.
Moderator - Iwona Świątczak-Wasilewska, PhD in Area and Cultural Studies (North American Studies) from the University of Helsinki, Americanist, English scholar (Tampere University, Finland); scholarship holder of US presidential foundations, including Theodore Sorensen Research Fellow (Boston, MA). She specialises in American political communication. Member of the American Professional Speechwriters Association and the European Speechwriters Network. She has provided training for European Commission speechwriters. She cooperates with cultural institutions on Polish-American projects. At the invitation of the Public Relations Companies Association, she sat on the jury of the 'Golden Clips' competition, the oldest public relations competition in Poland, which aims to raise professionalism and standards in the public relations industry.
You cannot miss such an opportunity!

Professional Barista training with the ‘Książką i Kawą’ ('Book and Coffee') café
Can't imagine a day without coffee? Do you want to learn how to brew the perfect espresso or cappuccino with frothed milk like in the best coffee shops? Become an expert in professional coffee making at home!
The 'Ksiazką i Kawą' café is joining the GOCC campaign by staging a professional barista workshop!
The training is ideal for people who want to start their adventure with professional coffee making. It combines a theoretical and a practical part.
The training programme includes:
- THEORY: The history of coffee - The path from bean to cup of coffee - What the coffee roasting process is all about and how it affects the effect in the cup - Parameters for the correct brewing of espresso - Principles of milk frothing - How a cob machine works and how to take care of it?
- PRACTICE: How to make espresso - Learn how to froth milk properly - Make espresso-based black coffees and milk coffees - Latte Art basics (pouring and etching)
The workshop is designed for 1 or 2 participants, so you can invite an accompanying person.
It will take place in the 'Ksiazką i Kawą' café at the Faculty of Social Sciences, University of Gdańsk.
The date is to be determined individually, but no later than 31.12.2024. The café's preferred training period is during the holidays.
It is possible to conduct the training in English after informing the trainers of such a wish in advance.
The 'Ksiażką i Kawą' café team is made up of baristas trained by the best specialists in the country, for whom coffee is a daily passion.
You are welcome to bid! - before it will be too LATTE! ;)

Feeding the seals at the Marine Station of the Institute of Oceanography at the University of Gdańsk in Hel
You are invited to bid for a visit to the Marine Station in Hel, where you will be able to take part in the feeding and medical training of a breeding stock of grey seals under the guidance of experienced animal caretakers, as well as learn about the work of scientists on harbour porpoises.
The UG Marine Station named after prof. Krzysztof Skóra is a unique place. The scientific field station of the Institute of Oceanography at the University of Gdańsk is mainly involved in research and didactics on the nature and conservation of the Baltic Sea. In addition to its statutory activities, the Marine Station team also carries out projects for the active protection of marine nature and undertakes numerous information and educational initiatives. Part of the Marine Station complex is, among other things, the Porpoise House, which houses an exhibition devoted to research on porpoises - the only cetacean permanently inhabiting the Baltic Sea. Another part of the complex is also very popular, especially in the summer - the seal centre, which is the site of a project for the active protection of grey seals and serves for research and education. It is the main attraction of our auction - the person who bids for a visit to the Marine Station will have a unique opportunity to meet the seals eye to eye!
Due to the nature of the auction, only one person can join the activity.
The seals are already waiting for you!
Deadline: the implementation of the winning auction will be possible within six months from the date of the auction by prior telephone arrangement with the Marine Station Manager (tel. 58 6750 836).

Tour of the University of Gdańsk research vessel R/V Oceanograf in the harbour
See the most modern marine research vessel in Europe!
Up for auction is a unique opportunity to take an individual tour of the University of Gdańsk's scientific research vessel R/V Oceanograf. Your guide will be dr Jakub Idczak, who - during an approximately one-hour tour of the vessel - will demonstrate the vessel's research capabilities, including the specialised measuring apparatus used to study the sea.
Groups of up to 5 people are welcome.

An unforgettable cruise on the University of Gdańsk's scientific research vessel R/V Oceanograf!
Set sail on vast waters on the University of Gdańsk's scientific research vessel R/V Oceanograf! During the expedition, dr Jakub Idczak will demonstrate the ship's capabilities, including the specialised measuring equipment used in marine research. In addition, the cruise will take place over a wreck lying on the bottom of the Gulf of Gdansk, which will be an opportunity to record hydroacoustic data showing the location of the sunken vessel.
Duration of the cruise: 5-6 hours.
We can take a maximum of 5 people on the cruise.
Join us on this amazing journey!

Radio MORS 'behind the scenes'
Learn the ins and outs of working as a radio personality from both sides of the microphone. Undergo special training to use the radio equipment and play with your voice. Also, test yourself as a sound engineer and sit behind a mixing console. See how a playlist of songs is put together and how a news service is created.

A children's university set full of adventure and joy
The object of this auction is a one-of-a-kind set aimed at the little reader.
It includes the children's book 'Zuzia odwiedza Uniwersytet Gdański', a pillow-doll with the main character and a puzzle with the same motif.
The book tells the adventures of a resolute 7-year-old girl, Zuzia - the daughter of University of Gdańsk academics, who visits the Oliwa Campus of the University of Gdańsk with her dad. The author of the little heroine's adventures is Agnieszka Beck, who drew her inspiration from observing how children perceive the space of the University of Gdańsk. Zuzia's expression was highlighted by Dominika Konkol, who created beautiful, colourful illustrations showing the girl's walk around the campus.
The book is also the result of the work of other members of the Promotion and Sponsor Relations Team, the Press Team and the University of Gdańsk Printing Department.
Agnieszka Beck - author of the book ‘Zuzia odwiedza Uniwersytet Gdański’ - works in the Promotion and Contact with Sponsors Team, where she is mainly responsible for the creative part of the team's work, branding, content marketing and event organisation. Mum of a curious, clever and empathetic 3-year-old. By writing a children's book, which is the first part of the series of Zuzia's adventures, Agnieszka made one of her childhood dreams come true.
Dominika Konkol - illustrator and graphic designer in the Promotion and Contact with Sponsors Team and a student of the Polish-Japanese Academy of Information Technology in the field of graphic design. She has been interested in drawing since childhood and in digital graphics since the age of 12. Winner of many art and graphics competitions. She is the author of illustrations in the book ‘Zuzia odwiedza Uniwersytet Gdański’.

Unique, personalised illustration based on a photo
Bid for an illustration made especially for you of a person, people (not more than 5) or an animal in the style shown. The illustration will be created on the basis of several submitted photographs and a short description, in which you can include additional requests such as backgrounds or character attributes.
The illustration will be made using a graphics program. Completion time to be agreed individually, but no longer than one month.
The illustration will be delivered in an IKEA frame (model: RIBBA, colour: black, size: 30x40 cm) and electronic form (jpg and pdf).
Dominika Konkol - illustrator and graphic designer in the Promotion and Contact with Sponsors Team and a student at the Polish-Japanese Academy of Information Technology in the field of graphic design. She has been interested in drawing since childhood and in digital graphics since the age of 12. Winner of many art and graphics competitions. She is the author of the illustrations in the book 'Zuzia na Uniwersytecie'.
Bid for this wonderful gift for yourself or someone close to you!
Training with the volleyball players of JohnnyBros AZS University of Gdańsk
You have a unique opportunity to bid for a training session with the volleyball players of JohnnyBros AZS University of Gdańsk. The players play in the second league and, therefore, know exactly what advice to give to train you effectively in volleyball serves, attack, or defence. There is a lot to fight for!
The training will be conducted by Rafał Murczkiewicz - in the past, an assistant in extraliga teams such as Trefl Sopot or MKS Będzin, as well as the 1st Coach of SWD Powervolleys Düren (Germany). Currently 1st Coach of the JohnnyBros AZS University of Gdańsk team.
Training date to be determined individually. To be used within six months of the announcement of the auction result.
We look forward to seeing you under the net!
'Turbokozak' - Try yourself during the men's futsal section training
Are you a fan of futsal? Do you play this sport? Or maybe you just want to try your hand at shooting on goal - and in the company of professionals: players of the men's futsal section (1st league)?
Take part in the auction and win the opportunity to take part in turbo contests during the training of our futsal section, which will allow you to test and improve your skills.
We have prepared the following competitions for you, among others:
- 'One-on-one' - the player must win the duel with the goalkeeper
- 'Don't spin to score' - the player makes 15 spins around the ball lying on the ground (while doing so, he must constantly touch the ball with his hand) and then has to score a penalty on an empty goal
- 'Hit the crossbar' - the player's task is to hit the crossbar by shooting from the line of the penalty area
- 'Half' - the player's task is to hit an empty goal, shooting from the middle of the field (the ball must not bounce off the ground).
The training date is to be agreed upon individually with coach Wojciech Pawicki, a former player of the Polish national team and Futsal Ekstraklasa teams. To be used within six months of the announcement of the auction result.
Sport, fun, and a hefty dose of emotions at the highest level guaranteed!
Are you ready?

Vocal Studio UG concert - just for you and your guests
Musically talented singers from the UG Vocal Studio will sing at a venue and repertoire of your choice, especially for you and your guests!
Are you organising a conference, a banquet, a business meeting or want to surprise your family, friends or acquaintances? This is the perfect way to make your event or the occasion you are celebrating unique and unforgettable!
Duration of the concert: up to 45 minutes
Venue: to be determined and organised by the auction winner (minimum space for the band is 8m x 2m or 7m x 3m)
Repertoire: to be arranged (e.g. Polish music, Christmas songs/carols or others in the band's current repertoire)
Concert date: to be determined individually, no later than 31.12.2024.
Depending on the chosen repertoire, the ensemble members will perform solo or group songs to instrumental backings during the concert.
Notably, the sound system, lighting, and stage preparation are the responsibility of the auction winner, who is the concert organiser. We provide the vocalists and the perfect atmosphere :)
The University of Gdańsk Vocal Studio is an artistic group which has been active for two years at the Alternator Academic Cultural Centre of the University of Gdańsk. The group brings together musically talented female students and PhD students, who have the opportunity to develop their vocal skills as part of the Studio's activities. Currently, the ensemble is made up of 9 female students and one female PhD student of the University of Gdańsk, who, under the watchful eye of Krzysztof Majda - a vocalist, vocal instructor and music producer from the Tricity - actively perform, record and shape their stage personalities.
Despite their short experience, the band has made themselves at home at the University of Gdańsk and has already recorded studio sessions and music videos, taken part in the award-winning performance 'Szymborska: collage', and, most importantly, played dozens of concerts, including major music projects such as the flagship 'Adele Songbook' (performed at the Baltic Philharmonic and the Kashubian Philharmonic, among others), the All Souls' Day concert 'Tyle było dni', or the latest project 'Beat it, ladies! Michael Jackson in the female version', with which the band performed, among others, in Stary Maneż, Chatka Żaka in Lublin or during the Pomeranian Sports Gala in the European Solidarity Centre.

Professional studio recording with music producer Krzysztof Majda
If you dream of having your song or cover song professionally recorded to share with your family and friends or make it available online, then this auction is made for you!
Take part in the auction, and you will record and produce your dream song under the guidance of an experienced singing instructor and Tri-City music producer - Krzysztof Majda /MYDA.
Deadline for recording and music production: to be agreed upon directly with the instructor no later than the end of 2024.
Place: Akademickie Centrum Kultury UG, 58 Wita Stwosza St., Gdańsk
Estimated time to work on the material: 2 to 5 hours
Krzysztof Majda - vocalist, instrumentalist, vocal coach, music producer, songwriter and arranger, Master of Arts, jazz vocalist graduate of the Stanisław Moniuszko Academy of Music in Gdańsk. In 2017, he released the album 'Bieg zdarzeń. Tribute to Turnau'. He performs on many Polish music stages. He had the pleasure of co-performing with Anna Wyszkoni, Stanislaw Soyka, Tadeusz Woźniak and the Zakopower band during a concert to celebrate the 100th anniversary of regaining independence at London's Royal Albert Hall. Since 2021, he has been the artistic manager of the Vocal Studio of the University of Gdańsk, operating at the Academic Cultural Centre of the University of Gdańsk 'Alternator', as part of which he has realised original projects known to the Gdańsk audience, such as 'Adele Songbook' (Baltic Philharmonic, Kashubian Philharmonic), 'So many were the days' (Shakespeare Theatre), or 'Beat it, ladies! Michael Jackson in a Women's Edition' (Stary Maneż).
Don't miss such an opportunity - we'll be in the studio to hear it ;)
